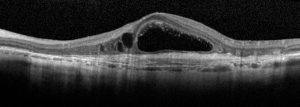

La tomografia a coerenza ottica (OCT) è un test di imaging non invasivo che utilizza le onde di luce per scattare foto della retina, e in particolare della macula. La macula è una parte della retina deputata alla visione a colori e ad alta definizione.


Con l’OCT possono essere analizzati e mappati tutti gli strati retinici, inoltre è possibile rilevare lo spessore retinico. Questi dati aiutano a effettuare una corretta diagnosi e a fornire delle indicazioni per il trattamento del glaucoma e delle patologie retiniche, malattie come la degenerazione maculare senile e la retinopatia diabetica.
Se in atto è presente o è stata presente una di queste condizioni retiniche è importante eseguire l’OCT.